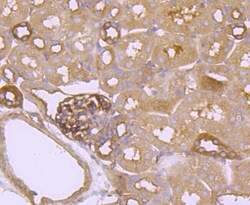

Antibody data
- Antibody Data
- Antigen structure
- References [2]
- Comments [0]
- Validations
- Immunocytochemistry [3]
- Immunohistochemistry [4]
- Flow cytometry [1]
- Other assay [1]
Submit
Validation data
Reference
Comment
Report error
- Product number
- MA5-32620 - Provider product page

- Provider
- Invitrogen Antibodies
- Product name
- FGFR3 Recombinant Rabbit Monoclonal Antibody (JM110-33)
- Antibody type
- Monoclonal
- Antigen
- Synthetic peptide
- Description
- Recombinant rabbit monoclonal antibodies are produced using in vitro expression systems. The expression systems are developed by cloning in the specific antibody DNA sequences from immunoreactive rabbits. Then, individual clones are screened to select the best candidates for production. The advantages of using recombinant rabbit monoclonal antibodies include: better specificity and sensitivity, lot-to-lot consistency, animal origin-free formulations, and broader immunoreactivity to diverse targets due to larger rabbit immune repertoire.
- Reactivity
- Human, Mouse, Rat
- Host
- Rabbit
- Isotype
- IgG
- Antibody clone number
- JM110-33
- Vial size
- 100 µL
- Concentration
- 1 mg/mL
- Storage
- Store at 4°C short term. For long term storage, store at -20°C, avoiding freeze/thaw cycles.
Submitted references Mahuang Decoction Attenuates Airway Inflammation and Remodeling in Asthma via Suppression of the SP1/FGFR3/PI3K/AKT Axis.
Targeting fibroblast growth factor receptors to combat aggressive ependymoma.
Wei L, Gou X, Su B, Han H, Guo T, Liu L, Wang L, Zhang L, Chen W
Drug design, development and therapy 2022;16:2833-2850
Drug design, development and therapy 2022;16:2833-2850
Targeting fibroblast growth factor receptors to combat aggressive ependymoma.
Lötsch D, Kirchhofer D, Englinger B, Jiang L, Okonechnikov K, Senfter D, Laemmerer A, Gabler L, Pirker C, Donson AM, Bannauer P, Korbel P, Jaunecker CN, Hübner JM, Mayr L, Madlener S, Schmook MT, Ricken G, Maaß K, Grusch M, Holzmann K, Grasl-Kraupp B, Spiegl-Kreinecker S, Hsu J, Dorfer C, Rössler K, Azizi AA, Foreman NK, Peyrl A, Haberler C, Czech T, Slavc I, Filbin MG, Pajtler KW, Kool M, Berger W, Gojo J
Acta neuropathologica 2021 Aug;142(2):339-360
Acta neuropathologica 2021 Aug;142(2):339-360
No comments: Submit comment
Supportive validation
- Submitted by
- Invitrogen Antibodies (provider)
- Main image

- Experimental details
- Immunocytochemical analysis of FGFR3 in MCF-7 cells using a FGFR3 Monoclonal antibody (Product # MA5-32620) as seen in red. The nuclear counter stain is DAPI (blue). Cells were fixed in paraformaldehyde, permeabilised with 0.25% Triton X100/PBS.
- Submitted by
- Invitrogen Antibodies (provider)
- Main image

- Experimental details
- Immunocytochemical analysis of FGFR3 in HepG2 cells using a FGFR3 Monoclonal antibody (Product # MA5-32620) as seen in red. The nuclear counter stain is DAPI (blue). Cells were fixed in paraformaldehyde, permeabilised with 0.25% Triton X100/PBS.
- Submitted by
- Invitrogen Antibodies (provider)
- Main image

- Experimental details
- Immunocytochemical analysis of FGFR3 in SH-SY5Y cells using a FGFR3 Monoclonal antibody (Product # MA5-32620) as seen in red. The nuclear counter stain is DAPI (blue). Cells were fixed in paraformaldehyde, permeabilised with 0.25% Triton X100/PBS.
Supportive validation
- Submitted by
- Invitrogen Antibodies (provider)
- Main image

- Experimental details
- Immunohistochemical analysis of FGFR3 of paraffin-embedded Human kidney tissue using a FGFR3 Monoclonal antibody (Product #MA5-32620). Counter stained with hematoxylin.
- Submitted by
- Invitrogen Antibodies (provider)
- Main image

- Experimental details
- Immunohistochemical analysis of FGFR3 of paraffin-embedded Mouse testis tissue using a FGFR3 Monoclonal antibody (Product #MA5-32620). Counter stained with hematoxylin.
- Submitted by
- Invitrogen Antibodies (provider)
- Main image
- Experimental details
- Immunohistochemical analysis of FGFR3 of paraffin-embedded Mouse kidney tissue using a FGFR3 Monoclonal antibody (Product #MA5-32620). Counter stained with hematoxylin.
- Submitted by
- Invitrogen Antibodies (provider)
- Main image

- Experimental details
- Immunohistochemical analysis of FGFR3 of paraffin-embedded Mouse brain tissue using a FGFR3 Monoclonal antibody (Product #MA5-32620). Counter stained with hematoxylin.
Supportive validation
- Submitted by
- Invitrogen Antibodies (provider)
- Main image

- Experimental details
- Flow Cytometric analysis of FGFR3 in A549 cells using a FGFR3 Monoclonal Antibody (Product # MA5-32620) at a dilution of 1:50, as seen in red compared with an unlabelled control (cells without incubation with primary antibody; black). Alexa Fluor 488-conjugated goat anti rabbit IgG was used as the secondary antibody.
Supportive validation
- Submitted by
- Invitrogen Antibodies (provider)
- Main image

- Experimental details
- Fig. 6 Targeting FGFR inhibits MAPK and PI3K pathway activation, induces differentiation and is applicable in the clinic. a Effects of long-term treatment (24 h) with ponatinib (Pon) and nintedanib (Nin) on FGFR1 and FGFR3, on PLCgamma, MAPK and PI3K signaling activation (indicated by changes in the phosphorylation status) in PF-A (BT214) and ST-RELA (VBT211) cells was analyzed by Western blot. ss-actin served as a loading control. b Immunohistochemical staining of FGFR3 in tissue section of VBT242 at resection prior to FGFRi treatment is depicted. c Cell viability of VBT242 upon treatment with the FGFR inhibitor nintedanib and the FGFR/multikinase inhibitor ponatinib, compared to avapritinib and dasatinib targeting PDGFRA and Src, respectively, was determined and is expressed as dose-response curve. Representative pictures at 72 h nintedanib exposure (5 uM) are depicted above. Intracellular accumulation of the drug is verified by the green fluorescence photomicrograph. d Course of disease and treatment regimen in a patient suffering from ST-RELA EPN (corresponding to the VBT242 model). Time zero represents the time when the patient was admitted to our center for treatment of the 5th recurrence. The timeline indicates therapeutic interventions and clinical course. MEMMAT-like therapy was carried out as previously published [] and NCT01356290. Tumor manifestations are indicated with white arrows on axial und coronal contrast-enhanced T1-weighted magnetic resonance images (MRI)
 Explore
Explore Validate
Validate Learn
Learn Western blot
Western blot Immunocytochemistry
Immunocytochemistry